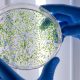

A Föld szinte minden szegletét beborítja a műanyag, a tengerpartoktól a hegycsúcsokig. Az egyszer használatos termékek ugyan megkönnyítik a mindennapokat, de közben hozzájárultak az emberiség egyik legsúlyosabb környezeti válságához. A kérdés egyre égetőbb: képesek vagyunk még megfékezni a műanyagszennyezést?
A műanyag története alig több mint százéves. A belga vegyész, Leo Baekeland 1907-ben alkotta meg az első teljesen szintetikus műanyagot, amely forradalmasította az ipart. Könnyű, tartós és olcsó anyag volt, ami tökéletesen illeszkedett a 20. század gyorsan modernizálódó világához. A második világháború után a termelés robbanásszerűen nőtt, a műanyag pedig az élet minden területére betört az orvostechnikától a közlekedésen át az űrkutatásig. Műanyag nélkül ma elképzelhetetlen lenne a világ.
Ám miközben a műanyag az emberiség egyik leguniverzálisabb találmánya lett, egyben az egyik legnagyobb kihívásunkká is vált. Az olcsósága és sokoldalúsága elindította az „eldobható kultúrát”, ma már a műanyagok 40 százaléka egyszer használatos termék formájában hasznosul. A PET palackok, szatyrok vagy ételcsomagolások gyakran csak percekig szolgálnak minket, mégis akár több száz évig is a természetben maradnak.
Az elmúlt hetven évben a műanyaggyártás szinte felfoghatatlan mértékben nőtt: míg 1950-ben alig 2 millió tonnát állítottak elő világszerte, 2015-re ez a szám elérte a 448 milliót, és a becslések szerint 2050-re ez a szám meg is megduplázódhat. Minden évben körülbelül nyolcmillió tonna műanyag hulladék kerül az óceánokba, tengerekbe, ami olyan, mintha a világ összes vízpartjára méterenként öt szemeteszsákot dobnánk le. A szennyezés leglátványosabban Ázsiában és Afrikában jelenik meg, ahol a hulladékgyűjtés és -kezelés gyakran hiányos. De a fejlett országok sem kivételek, sok helyen az alacsony újrahasznosítási arány miatt hatalmas mennyiségű szemét végzi égetőkben vagy a természetben.
A napfény, a szél és a hullámok hatására a műanyag apró darabokra, mikroműanyagokra bomlik, amelyek ma már a világ minden részén jelen vannak. A Mount Everest hófedte csúcsaitól a Mariana-árok mélyéig, sőt az ivóvízben és a levegőben is kimutathatók. A kutatók már az emberi vérben, tüdőben és emésztőrendszerben is találtak mikrorészecskéket. Bár még vizsgálják, pontosan milyen hatással van mindez az egészségünkre, egyre több bizonyíték utal arra, hogy a mikroműanyagok gyulladást, sejtkárosodást és hormonális zavarokat is okozhatnak.
Évente több millió állat pusztul el a műanyagszennyezés miatt. A tengeri madarak, halak, teknősök, sőt nagytestű emlősök is gyakran lenyelik a műanyagot, ami elzárja az emésztőrendszerüket, és így lassú éhhalált okoz. Ez mintegy 2100 fajt érint, köztük veszélyeztetetteket is, és ma már szinte nincs olyan tengeri madárfaj, amelynek gyomrában ne találtak volna műanyagot.
Probléma az is, hogy a tengerekbe jutott műanyagot szinte lehetetlen teljesen eltávolítani. Bár akadnak ígéretes technológiák, például a Baltimore-i „Trash Wheel”, amely mechanikusan gyűjti össze a hulladékot, ezek csak a nagyobb darabokat képesek kiszűrni. A mikroműanyagok azonban már a vízoszlop teljes mélységében lebegnek, és gyakorlatilag visszafordíthatatlanul beépültek a környezetbe. A megoldás ezért nem a tengerek „kitakarítása”, hanem a megelőzés lenne.
A szakértők szerint a kulcs a hulladékkezelési rendszerek fejlesztésében, az újrahasznosítás arányának növelésében és a gyártás csökkentésében rejlik. Egyre több ország vezet be műanyagzacskó-tilalmat vagy ösztönöz újrahasznosítható alternatívákat. Emellett a tudatos fogyasztói döntések is számítanak: ha kevesebb egyszer használatos terméket vásárolunk, ha újratölthető palackokat és csomagolásmentes megoldásokat választunk, máris sokat tehetünk az óceánok és saját jövőnk védelméért.
Forrás: Chikansplanet
Eredeti cikk: Műanyagszennyezés: a modern kor láthatatlan járványa
![]() |
2026
A munkavállalók és vállalatok alkalmazkodóképességének és termelékenységének javítása a munkaerő fejlesztésén keresztül” elnevezésű munkaerőpiaci programban nyújtott támogatás tárgyábanBővebben Cégünk részt vesz a Széchenyi Terv Plusz pályázaton, melynek célja munkavállalók és vállalatok alkalmazkodóképességének és termelékenységének javítása. Kedvezményezett neve: ALTEO Circular Korlátolt Felelősségű Társaság
Képzések részletes bemutatása: 1. Munkahelyi kompetenciafejlesztés I. (20 óra): 2. Digitális együttműködés és generációk közötti kommunikáció a munkahelyen (16 óra): 3. Digitális munkahelyi kompetenciafejlesztés III. (16 óra): 4. NIS 2 Információbiztonsági alapelvek és szabályozások (28 óra): 5. Digitális munkahelyi kompetenciafejlesztés II. (16óra): 6. Angol KER B2 középhaladó szintű nyelvi képzés (60 óra): Képzések tervezett befejezési dátuma : 2026.10.16. |
![]() |
2022
A munkavállalók és vállalatok alkalmazkodóképességének és termelékenységének javítása a munkaerő fejlesztésén keresztül” történő támogatásáról.Bővebben
A pályázat célja munkahelyi képzések megvalósítása az Éltex Kft. munkavállalói számára, ezzel növelve társaságunk hatékonyságát, eredményességét. A támogatást 2022. novemberében nyertük el, és ugyan ebben a hónapban kezdtük el a megvalósítást. Az Éltex Kft. az alábbi támogatásban részesült: Kedvezményezett neve: ÉLTEX Kereskedelmi és Fuvarozó Korlátolt Felelősségű Társaság Fejlesztés tárgya: A munkavállalók és vállalatok alkalmazkodóképességének és termelékenységének javítása a munkaerő fejlesztésén keresztül Iktatószám: HB/09-FOGL/004119-9/2022 Támogatás összege: 15 756 784 Ft Támogatás intenzitása: 50 % Tervezett befejezés időpontja: 2023.12.31. A projekt keretében megvalósuló képzések:
|
![]() |
2022
TDIJ-ÉMI-2022 Támogatási programBővebben Az Éltex Kft. támogatásban részesült az alábbiak szerint: Támogató: ÉMI Építésügyi Minőségellenőrző Innovációs Nonprofit Kft. A Támogatás célja: hogy a Magyar Állam az SA.58312 számú bizottsági határozaton alapuló, vissza nem térítendő költségvetési támogatás nyújtásával a termékdíj-köteles termékekből keletkezett hulladékok kezelésével/előkezelésével/hasznosításával foglalkozó, vagy a támogatással létrejövő fejlesztés révén azt megvalósító mikro-, kis- és középvállalkozások, valamint a nagyvállalkozások COVID-19 járvány (koronavírus-járvány) következtében kialakult likviditási nehézségeit enyhítse a körforgásos gazdaság megvalósulását elősegítő hazai komplex hulladékgazdálkodási rendszerek kialakításának, fejlesztésének, hatékonyságnövelésének, továbbá a másodnyersanyagok felhasználásának ösztönzése által. A támogatási Kérelem száma: TDIJ-ÉMI-2022-00022 A támogatói okirat dátuma: 2022.05.25. Iktatószám: 22-11/2022//TDIJ A támogatás összege: 163.743.709,- Ft A támogatás intenzítása: 70% A befejezés időpontja: 2023. szeptember 30. |